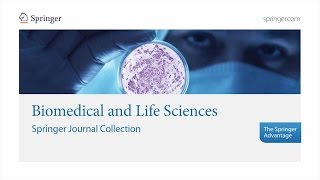

Spotlight On Cellular and Molecular Biosciences
Coventry University Research
Cellular and Molecular Organization of the Brain
Jeanette Norden, Professor of Cell and Developmental Biology, Emerita, Vanderbilt University School of Medicine, explores how the brain learns and ...
Vanderbilt University
Introducing Biochemistry and Cellular and Molecular Biology (BCMB)
The College of Arts and Sciences is the gateway to knowledge for every undergraduate student at UT. We are the largest, most diverse college and a central ...
UT Arts & Sciences
Biochemistry (Molecular and Cellular) at Oxford University
Want to know more about studying at Oxford University? Watch this short film to hear tutors and students talk about this undergraduate degree. For more ...
University of Oxford
Your Body's Molecular Machines
These are the molecular machines inside your body that make cell division possible. Animation by Drew Berry at the Walter and Eliza Hall Institute of Medical ...
Veritasium
Cell and molecular Size Comparison 2018
RED SIDE "STORE" is here : https://bit.ly/38JfIYv Background Music : Kevin MacLeod - Air Prelude CELL Structure of an animal cell The cell (from Latin cella, ...
RED SIDE
University of Dundee | Life Sciences | Biomedical and Molecular Sciences MSc
Considering a masters course in the field of life sciences? Take a look at our Biomedical and Molecular Sciences MSc - you'll get a robust grounding in ...
University of Dundee
Cellular Molecular Biology Lab
NanoscaleScience
Cellular and Molecular Biology, M.S.
For more information on a master's degree in Cellular and Molecular Biology visit ...
University of New Haven
Cell Biology, Genetics & Molecular Medicine
A look at the Cell Biology, Genetics & Molecular Medicine discipline of the Integrated Biomedical Sciences Ph.D. program at the Graduate School of Biomedical ...
Graduate School of Biomedical Sciences at UT Health San Antonio
Why study an MSc in Biophysics and Molecular Life Sciences at Bristol?
This new programme was created in response to an increasing need from both industry and academia. This MSc is aimed at graduates from both the life ...
University of Bristol
Book Discussion Lecture: Molecular Cell Biology by Harvey Lodish Chapter 7 Biomembrane Structure
Join our "LIVE ONLINE CLASSROOM COURSE" for New Batches for December CSIR NET Life Sciences are starting ...
TLS Online
A Message from the Department of Molecular and Cellular Biology
This video features remarks from Distinguished Professor Jodi Nunnari, Professor Ken Kaplan, Professor Francis McNally and Professor David Wilson.
UC Davis College of Biological Sciences
"Neuroscience Methods Update: Cellular and Molecular Neuroscience," Mike Kaplan, PhD
Penn Center for Neuroscience & Society
Graduate Program in Molecular Biology, Cell Biology, and Biochemistry
The Graduate Program in Molecular Biology, Cell Biology, and Biochemistry at Brown.
Alpert Medical School
Master of Science in Cellular and Molecular Biology: Advanced Training for Successful Research
Christina Zito, assistant professor and coordinator of the University of New Haven's master's degree program in cellular and molecular biology, describes how ...
University of New Haven
Master Molecular Life Sciences at HAN University of Applied Sciences
HAN University of Applied Sciences is university situated in Arnhem and Nijmegen, Netherlands. It is considered to be one of the top educational institutions in ...
UNIFY - Study in Holland
Molecular Biologist: Job Profile
Harveen Dhariwal talks about her job at life sciences company Ingenza, where she works as a scientist in the molecular biology department. In this video she ...
My World of Work
Top 10 Lab Techniques Every Life Science Researcher Must Know!
Top 10 Lab Techniques Every Life Science Researcher Must Know! Read More - https://btnk.org/lab-technique #Labtechnique #LifeScienceSkills.
Biotecnika
Cellular and Molecular Biology - Cell Basics
A video describing the basics of cell biology. This is my first video, show some support by giving suggestions below! Thanks for watching :')
StudentcastLectures
Lodish Molecular Biology- Ch 1 Lec 1 The Dynamic & Architecture of Cells
Download app & Purchase this code Link- https://play.google.com/store/apps/details?id=co.khal.sls&hl=en Syllabus Outlines : Contents: In Brief TABLE OF ...
Sanmish Life Sciences
Cell and Molecular Biology Animations | Promotional Demo
This is our new promotional demo video showcasing some of our recent work on several cellular and molecular biological processes. Our Smart Biology Course ...
Smart-Biology
These 3D animations could help you finally understand molecular science
Art and science have in some ways always overlapped, with early scientists using illustrations to depict what they saw under the microscope. Janet Iwasa of the ...
PBS NewsHour
HAN Master | Molecular Life Sciences I Deeya's Story (English subtitles)
HAN Master | Molecular Life Sciences I Deeya's Story Deeya from India follows the full-time masters course Molecular Life Sciences. She works at TropIQ Health ...
HAN University of Applied Sciences
Cellular & Molecular Boundaries of Human Performance: 55 Min Phys
Dr. Galpin tackles the cellular foundations human performance in part 1 (0-30 min). Dr. Tobias goes into detail about how the molecular environment regulates ...
Andy Galpin
CELS 191 Cell and Molecular Biology
Discover what it's like to study CELS 191 as part of Health Sciences First Year (HSFY), at the University of Otago. http://www.otago.ac.nz/hsfy.
University of Otago
Molecular Probes Tutorial Series—Analyzing Flow Cytometry Data
This tutorial on flow cytometry data analysis demonstrates the key aspects of data collection, processing and compensation. Learn more: ...
Thermo Fisher Scientific
All-atom Molecular Dynamics Simulation of the Bacterial Cytoplasm
How biomolecules behave in crowded cellular environments has been an important question in life science. Researchers at RIKEN and Michigan State ...
rikenchannel
Master Program Molecular Plant Science
The Master of Science in Molecular Plant Science is a consecutive and research-oriented degree program. Graduates will have learned molecular biological, ...
Universität Hamburg
Ron Vale (UCSF, HHMI) 1: Molecular Motor Proteins
https://www.ibiology.org/cell-biology/motor-proteins/ Molecular motor proteins are fascinating enzymes that power much of the movement performed by living ...
iBiology
Molecular Probes Tutorial Series—Introduction to Flow Cytometry
This tutorial on flow cytometry looks at the systems that make up the flow cytometer and how those systems work together to collect information on cells as they ...
Thermo Fisher Scientific
Tasneem Muna Shares Her Tips To Excel in Life Sciences!
Tasneem Hassan Muna is a PhD candidate in Cellular and Molecular Life Sciences at the University of Wyoming, USA. Career Solutions Bangladesh and CS ...
Career Solutions
Kyoto University, Graduate School of Biostudies, Cellular and Molecular Biomechanics
Kyoto University, Graduate School of Biostudies Division of Systemic Life Science Laboratory of Cellular and Molecular Biomechanics Prof. Taiji Adachi 京都 ...
Kyoto-U OCW
Sport and Exercise Science Research in the Life Sciences Building: Dr Adam Sharples
Liverpool John Moores University
Humsa Venkatesh, Category Winner 2019 – Molecular Medicine
Title of essay: The Neural Regulation of Cancer: Cancers hijack mechanisms of neural plasticity to promote malignant disease progression Biography: Humsa ...
Science & SciLifeLab Prize for Young Scientists
Biomedical and Life Sciences – Springer Journal Collection
With over 360 journals, the Springer Biomedical and Life Sciences program serves research and academic communities around the globe, covering the fields of ...
SpringerVideos
Molecular Cell Biology Quiz - MCQsLearn Free Videos
Learn molecular cell biology quiz oon MCQsLearn, a free website http://mcqslearn.com for exam preparation. Practice MCQs with molecular cell biology quiz, ...
Bushra Arshad
CSIR UGC NET suggestions - molecular biology
This CSIR NET suggestions lecture on molecular biology will help you to study NET topics and crack NET life sciences with guidance from Shomu's Biology.
Shomu's Biology
Cell and Molecular Biology: Vesicular Budding and Fusion
Learn how transport vesicles form and fuse with their target membranes. Click the info button at the top right corner to find more tutorials, quiz questions and an ...
Draw it to Know it - Medical & Biological Sciences
The Molecular Basis of Life
These animations show cellular biology on the molecular scale. The structure of chromatin, the processes of transcription, translation, DNA replication, and cell ...
James Tyrwhitt-Drake
Vesicle trafficking || vesicle transport in cell || molecular mechanism
This video describes the vesicular transport process in details. It also talks about anterograde and retrograde transport. Anterograde transport, as indicated by ...
Animated biology With arpan
Applications of Molecular Biology in Medical Sciences !!!
Scholar Idea